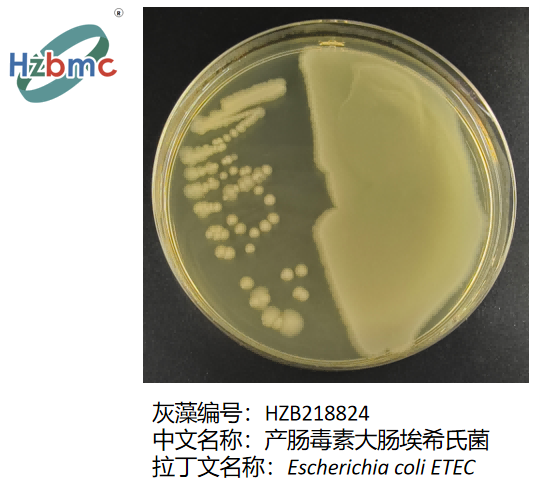
图2.产肠毒素大肠埃希氏菌(Escherichia coli ETEC)在琼脂平板上的菌落形态
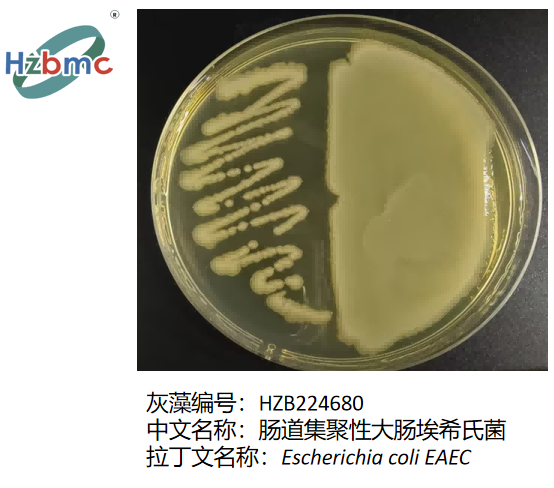
图3.肠道集聚性大肠埃希氏菌(Escherichia coli EAEC)在琼脂平板上的菌落形态

致病性大肠杆菌的多样性、致病机制与公共卫生防控
来源:武汉市灰藻生物科技有限公司 浏览量:328 发布时间:2026-01-19 19:12:46
一、简介
1.1 致病性大肠杆菌的疾病谱
致病性大肠杆菌(Pathogenic Escherichia coli)可引起多种疾病,包括新生儿脑膜炎(neonatal meningitis)、胃肠炎(gastroenteritis)、尿路感染(urinary tract infections, UTIs)、溶血性尿毒综合征(hemolytic-uremic syndrome, HUS)、腹膜炎(peritonitis)、肺炎(pneumonia)、乳腺炎(mastitis)和败血症(septicemia)。
1.2 大肠杆菌的双重角色:从益生潜力到病原威胁
大肠杆菌(Escherichia coli)是一种普遍存在且具有多重功能的细菌(ubiquitous and multifaceted bacterium)。它在生物学研究中具有重要价值,尤其在重组DNA技术(recombinant DNA technology)中被广泛使用,并作为载体(vector)用于生产有用的蛋白质、抗原等。大肠杆菌属于肠杆菌科(Enterobacteriaceae)中的埃希氏菌属(genus Escherichia),是典型的“大肠菌群”(coliform group)成员。据称,它是最早定植于婴儿肠道的细菌之一——出生后40小时内即可在结肠黏膜上附着,不仅可抵御外来肠道病原体的入侵,还能合成有益分子如维生素K(vitamin K),因此具备作为益生菌(probiotics)的潜力。

图1.大肠杆菌(Escherichia coli)的扫描电镜图像(SEM)
1.3 传播途径与环境卫生指示意义
肠道菌群中约有0.1%为大肠杆菌,其传播途径主要为粪–口途径(faecal–oral route)。一旦在水体、沙拉、豆芽、厨房用具、饮用水等环境样本中检出大肠杆菌,即表明存在粪便污染(faecal contamination)。
1.4 系统发育与基因组多样性
根据系统发育(phylogenic)关系,大肠杆菌可分为六个进化群;而全基因组测序(whole genome sequencing)研究则将其划分为五个亚种(A–E)。但这种分类与致病性无直接关联:A群包含所有用于科研的菌株,E群则包括O157:H7型大肠杆菌的一个分支。值得注意的是,并非所有肠出血性大肠杆菌(enterohemolytic E. coli, EHEC)在遗传上都密切相关。
1.5 水平基因转移与毒力演化
大肠杆菌具有高度遗传多样性(genetically diverse),仅有约20%的基因在不同菌株间共享。其基因可通过接合(conjugation)和转导(transduction)进行水平转移(horizontal gene transfer),从而在现有种群中扩散遗传物质。其中,转导依赖噬菌体(bacteriophage)介导;例如,志贺毒素(Shiga toxin)编码基因即由志贺氏菌(Shigella)通过噬菌体转移至O157:H7型大肠杆菌。
1.6 基本生物学特性
大肠杆菌为革兰氏阴性(Gram-negative)、杆状、不产芽孢(non-sporing)细菌,具有周生鞭毛(peritrichous flagella),因而具有运动能力(motile)。它属于兼性厌氧菌(facultative anaerobe),最适生长温度为37°C(部分实验室菌株可在49°C下生长),在理想条件下每20分钟即可分裂一次。
1.7 血清分型基础:O、H、K抗原系统
大肠杆菌菌株通常通过抗原组合进行鉴定,包括O抗原(脂多糖,somatic lipopolysaccharide)、H抗原(鞭毛蛋白,flagellin)和K抗原(荚膜多糖,capsular polysaccharide),例如O157:H7。目前已知约有190个血清群(serogroups)。
O抗原由三部分组成:(a) 具有免疫原性的重复寡糖聚合物;(b) 磷酸化的非重复寡糖核心;(c) 脂质内毒素(lipid endotoxin)。目前已鉴定出O1至O181等多种O抗原,其中O31、O47、O67等以及O174至O181为暂定命名;部分还存在亚型,如O128ab和O128ac。
H抗原有H1至H56,但H13和H22并非大肠杆菌。
K抗原(荚膜抗原)为酸性多糖,呈厚实黏液状包裹细胞,编号为K1至K60。根据分子量可分为三类:KI型(约100 kDa)、II型(<50 kDa,常与肠外感染相关)和III型(介于两者之间,如K3、K10、K54/K96)。
二、致病性大肠杆菌(Pathogenic E. coli)
致病性大肠杆菌可引起动物和禽类多种疾病,如新生犊牛腹泻与败血症、奶牛急性乳腺炎及大肠杆菌病(colibacillosis)。此外,它还可与其他弱致病菌协同,在各类动物组织中引发炎症,如心包炎(pericarditis)、腹膜炎(peritonitis)、肝周炎(peri-hepatitis)等。
在人类中,大肠杆菌是胃肠炎和尿路感染的常见病因。其致病途径多样:可通过内源性途径(如泌尿道)或外源性途径(如伤口、肠道)侵入机体。健康牛及其他动物可成为无症状携带者(shedders),通过受污染的食物和水源将病原传给人类;人与人之间的直接传播亦可发生。
Alizade等人(2019)对73项研究、共18,068株分离株进行荟萃分析,发现致泻性大肠杆菌(diarrhoeagenic E. coli, DEC)的分布如下:
- 产肠毒素型(ETEC):16%
- 聚集黏附型(EAEC):11%
- 肠致病型(EPEC):11%
- 志贺毒素产生型(STEC):9%
- 弥散黏附型(DAEC):6%
- 肠侵袭型(EIEC):4%
- 图2.产肠毒素大肠埃希氏菌(Escherichia coli ETEC)在琼脂平板上的菌落形态
- 图3.肠道集聚性大肠埃希氏菌(Escherichia coli EAEC)在琼脂平板上的菌落形态
伊朗地区的流行率较低。Nobili等人(2017)指出,2015年欧盟报告的志贺毒素型大肠杆菌(verotoxic E. coli, VTEC)感染为第四大常见人畜共患病(zoonosis),共5901例。其中,O157、O26、O103、O145、O111和O104等六个血清群构成重要的食源性公共卫生威胁。
2015–2016年意大利肉类污染调查显示:250份样本中,8.4%(21份)检出vtx毒素基因,2%成功分离出VTEC菌株,且这些菌株遗传背景多样,来源包括生绞牛肉、牛肉汉堡和生牛肉薄片(carpaccio)。
致病性大肠杆菌的来源为人和动物排泄物,凡被其污染的食物和饮品均可成为传染源。传播途径为粪–口途径。流行病学调查常追溯至以下原因:使用粪肥施肥或灌溉作物、污水污染水源、厨房交叉污染等。常见高风险食品包括生食(如豆芽、黄瓜、沙拉)及未充分加热的食品(如未经巴氏杀菌的果汁、牛奶和肉类)。在畜禽养殖环境中,苍蝇、直接接触甚至空气传播也可能发生。从业人员个人卫生不良亦是重要风险因素。
三、与食物中毒/胃肠炎相关的大肠杆菌(E. coli Associated with Food Poisoning/Gastroenteritis)
3.1 侵袭性大肠杆菌(Invasive E. coli)
侵袭性大肠杆菌在以下两种情况下大量存在:
- 炎症性肠组织中,其数量与炎症严重程度正相关;
- 溃疡性结肠炎(ulcerative colitis)和克罗恩病(Crohn’s disease)患者的肠黏膜中。
大肠杆菌是常见的食源性致病菌,多因食用未洗净的蔬菜或未充分烹煮的污染肉类所致。婴幼儿、老年人及免疫功能低下者病情尤为严重,部分菌株可产生致命毒素。
代表性血清型包括:O157:H7、O104:H4、O121、O26、O103、O111、O145 和 O104:H21。其中,O157:H7 属于肠出血性大肠杆菌(EHEC),可引起出血性腹泻;某些菌株兼具聚集黏附(enteroaggregative)和肠出血特性。
2006年,美国26个州报告了疑似大肠杆菌感染聚集病例。州公共卫生部门、CDC(疾病控制与预防中心)和FDA(食品药品监督管理局)联合开展调查并采取控制措施。183名患者中,52%需住院治疗,16%发展为溶血性尿毒综合征(HUS),1例于9月26日死亡。多数病例发病时间为8月19日至9月5日。回溯调查显示,95%的患者在发病前10天内曾食用生鲜菠菜。污染菠菜产自加州三个县。分离出的O157:H7菌株具有相同的脉冲场凝胶电泳(PFGE)图谱(MMWR, 2006年9月26日)。
2011年,O104:H4菌株在德国引发大规模食源性疾病暴发,表现为EHEC感染和HUS,需紧急医疗干预,并波及欧洲及北美共16个国家。近期,法国波尔多地区再次出现聚集病例,瑞典亦报告一例(来源:EFSA/ECDC联合风险评估报告及WHO欧洲区通报)。
3.2 志贺毒素产生型大肠杆菌(Shiga toxin-producing E. coli, STEC)
STEC可在7–50°C、pH ≥ 4.4、水分活度 ≥ 0.95的食品中生长。彻底加热(食品各部位达70°C以上)可有效灭活。STEC是严重食源性感染的常见病因,常见于生或未熟透的绞肉、生乳、蔬菜及豆芽(WHO, 2023)。
O121型STEC曾在美国6个州引发暴发,19人感染,44%需住院。源头追溯至受污染的生三叶草豆芽(clover sprouts)(CDC, 2014年8月1日最终通报)。
另一起O157:H7暴发波及美国四州,58%患者住院,疑因食用污染绞牛肉,涉事产品已下架。两起事件中均未出现HUS病例。
其他血清型也常导致散发或暴发病例。
大肠杆菌按毒力因子分类(Classification by Virulence Factors):
- 聚集黏附型(Enteroaggregative E. coli, EAEC): 人类致病株,引起无发热性腹泻;具有菌毛(fimbriae),可在体外使组织培养细胞聚集;黏附肠黏膜,产生热稳定肠毒素(ST)和溶血素(haemolysin),但不具侵袭性。
- 肠出血型(Enterohaemorrhagic E. coli, EHEC): 定植于人、牛、山羊肠道;引起无发热性出血性腹泻,可进展为HUS(突发肾衰竭)。其志贺毒素由噬菌体编码,引发强烈炎症,典型代表为O157:H7。
- 肠侵袭型(Enteroinvasive E. coli, EIEC): 人类致病株,引起类似志贺菌病(shigellosis)的剧烈腹泻伴高热。
- 肠致病型(Enteropathogenic E. coli, EPEC): 可感染人、犬、猫、马、兔等;通过名为“紧密素”(intimin)的黏附素结合宿主细胞,无菌毛;毒力因子与志贺菌相似,部分可产志贺毒素;可破坏肠上皮微绒毛(effacement),具中度侵袭性。
注:STEC O157:H7因对Vero细胞有毒性,又称“维罗毒素产生型”(Verotoxin-producing E. coli, VTEC);因其引起血性腹泻,亦称EHEC。其他如O145、O26、O111、O103等非O157 STEC菌株也可导致严重腹泻、HUS及肾衰竭,但鉴定更为复杂。
- 产肠毒素型(Enterotoxigenic E. coli, ETEC): 引起无发热性腹泻,常见于儿童、旅行者及多种家畜(羊、猪、牛、马、犬)。非侵袭性,依靠菌毛黏附肠上皮细胞(enterocytes),产生两类肠毒素:
四、临床症状(Symptoms)
潜伏期通常为1–3天,症状持续3–4天。多数患者仅需支持治疗(补液、电解质),无需抗生素或住院。常见症状包括:大量水样腹泻、腹痛、发热、恶心(伴或不伴呕吐)、厌食、寒战、头痛和肌痛(myalgia)。部分患者恢复缓慢,可达3周。少数可继发溶血性尿毒综合征(HUS),多见于5岁以下儿童,但各年龄段均可发生。
五、肠外感染(Extra-Intestinal Infections)
肠外组织感染可导致腹膜炎、HUS等。细菌可通过穿孔性溃疡、阑尾破裂或手术失误从肠道扩散至腹膜。
5.1 尿路致病性大肠杆菌(Uropathogenic E. coli, UPEC)
大肠杆菌占社区获得性尿路感染(UTI)的80–90%,医院获得性UTI的30–50%。约25%的女性在急性发作后6个月内复发。
基于三重PCR(triplex PCR),大肠杆菌可分为A、B1、B2、D四个系统发育群。肠外致病性大肠杆菌(ExPEC)主要属于B2和D群。一项针对印度阿拉哈巴德(Allahabad)和芒格洛尔(Mangalore)医院分离株的研究显示:70.6%的ExPEC属于B2/D群,B1最少见。四群菌株均可引起败血症,但B2/D群更常与UTI相关。B2群菌株感染更持久、严重,易导致复发与死亡,可产生生物膜(biofilm,促进初始黏附)、多种黏附素及溶血素(强毒力因子)。而A/B1群菌株多产β-内酰胺酶(beta-lactamase),耐药性强;B2群则多敏感。
UTI可能通过非自然性行为传播,此类菌株称为UPEC。女性因如厕后从前向后擦拭不当,或肛交后转为阴道性交,男性因肛交,均可导致肠道细菌进入泌尿生殖道。细菌可沿尿道上行至膀胱、肾脏(女性)或前列腺(男性)。由于女性尿道较短,UTI风险比男性高14倍。
致病机制包括:
- 肾盂肾炎菌毛(P-fimbriae):结合尿路上皮细胞上的P血型抗原(含D-半乳糖-D-半乳糖结构),部分人群因缺乏该受体而不易感。
- α/β溶血素:破坏未成熟红细胞及尿路上皮细胞,导致肾小管堵塞,引发HUS;微血栓可阻塞脑、肺、肾、四肢毛细血管,引起水肿,影响器官功能,升高血压。
- Dr家族黏附素:结合红细胞及多种细胞上的Dr血型抗原(Dra),诱导细胞膜包裹细菌,激活炎症反应,导致膀胱炎及妊娠期肾盂肾炎。
- 形成胞内细菌群落(IBC):逃避免疫系统的补体攻击。
- 产K抗原(荚膜多糖)菌株:多引起上尿路感染,其生物膜可抵抗免疫因子与抗生素。
- 血源性感染:罕见,细菌经血流播散至肾、膀胱、输尿管。
5.2 新生儿大肠杆菌脑膜炎(E. coli Neonatal Meningitis)
由携带K1抗原的菌株引起。新生儿经产道感染,肠道定植后发生菌血症。此阶段母体IgM抗体无法通过胎盘提供保护。更重要的是,K1抗原结构与脑组织糖肽(cerebral glycopeptides)高度相似,被机体识别为“自身抗原”,从而逃避免疫清除,引发严重脑膜炎。
此外,某些大肠杆菌可产生基因毒性物质大肠杆菌素(colibactin),在肠道黏膜屏障因并发感染受损时注入肠上皮细胞,损伤DNA,促进肿瘤发生(tumorigenesis)。
六、诊断(Diagnosis)
6.1 细菌培养(Bacterial Culture)
粪便或可疑食品接种于麦康凯琼脂(MacConkey agar)或伊红美蓝琼脂(EMB agar)。
- MacConkey上呈粉红色菌落;
- EMB上呈黑色带绿色金属光泽菌落。
进一步鉴定:
- 三糖铁(TSI)培养基:产酸/产酸/产气/不产硫化氢(A/A/g+/H₂S⁻);
- IMViC试验:吲哚(+)、甲基红(+)、VP(−)、枸橼酸盐利用(−),即 ++--。
通过哺乳动物细胞培养检测致病性,凝集试验(agglutination test)用于血清分型。
6.2 DNA指纹图谱(CDC PulseNet = PFGE)
对腹泻与非腹泻但共用可疑食物/水源/接触动物者的粪便中O157分离株进行PFGE分析。若图谱一致,则提示同源,可归因于特定暴露源,并据此追踪共同暴露人群以深入调查。
时间线参考:
- 潜伏期:1–3天;
- 样本采集窗口:症状出现至就医前1–5天;
- 实验室诊断:1–3天;
- PFGE分析:理想1天,实际2–4天;
- 加上运输时间:0–7天。
七、治疗(Treatment)
首要措施为补充丢失的液体和电解质。常用抗生素为氟喹诺酮类(fluoroquinolones)。应依据药敏试验(antibiotic susceptibility test)选择最适药物。
八、预防(Prevention)
关键在于个人卫生:
- 饭前便后、烹饪前后勤洗手;
- 厨房操作规范:生熟分开、避免交叉污染;
- 冷冻食品勿在室温解冻;
- 剩菜及时冷藏或冷冻保存。
参考文献
1.Alizade H, Teshnizi SH, Azad M, Shojae S, Gouklani H, Davoodian P, Ghanbarpour R (2019) An overview of diarrhoeagenic Escherchia coli in Iran: a systematic review and meta-analysis. J Res Med Sci 24:23
2.Nobili G, Franconieri I, La Bella G, Basanisi MG, Salandra GL (2017) Prevalence of verocytoxigenic Escherichia coli strains isolated from raw beef in southern Italy. Int J Food Microbiol 257:201–205
相关产品
HZB218822:产肠毒素大肠埃希氏菌 | Escherichia coli ETEC
HZB218826:志贺毒性大肠埃希氏菌 | Escherichia coli STEC
敬请关注灰藻生物,共筑健康未来!
— 武汉市灰藻生物科技有限公司团队敬上
灰藻生物:我们期待着与客户共同成长,共创生命科学的美好未来!
更新日期:2026-01-13
编制人:思琪
审稿人:小藻
